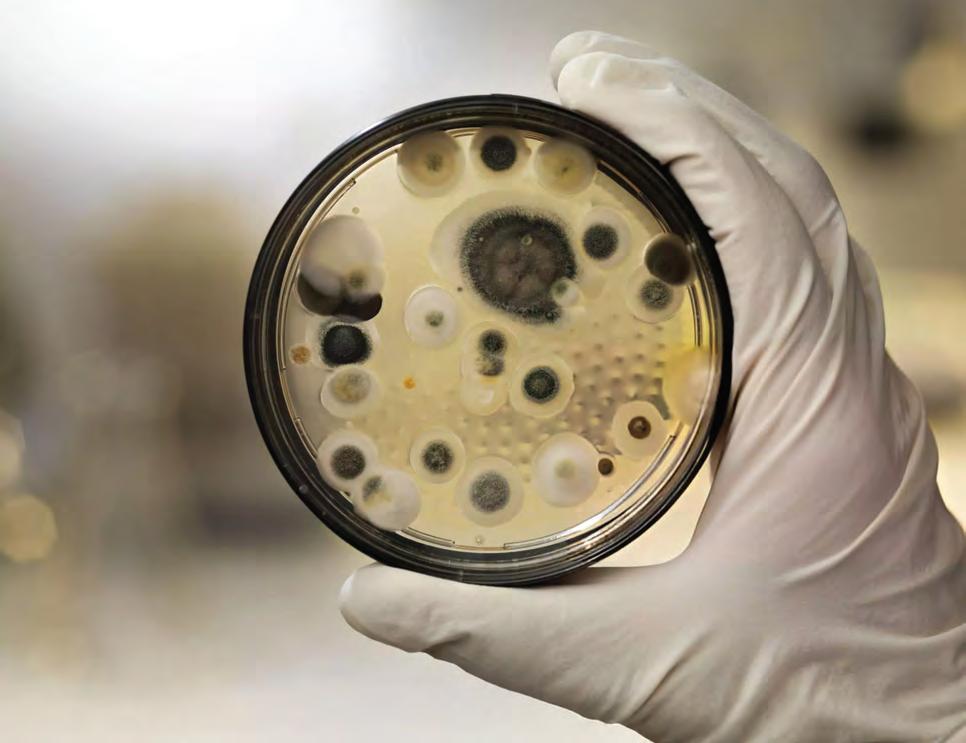

Legend at Moldy Oaks

Man claims Sandy landlord ignored the mold that was damaging his health.
BY SYDNEE CHAPMAN







Chapman

SLC FORECAST


![]()

Man claims Sandy landlord ignored the mold that was damaging his health.
BY SYDNEE CHAPMAN







Chapman



Everyone in Utah says they want to save the Great Salt Lake. Politicians nod solemnly, residents post aerial photos of receding shorelines, and state agencies roll out “strategic plans.”
And yet, here we are—again—on the brink of ecological collapse, with a lake that continues to shrink and a political class that continues to do absolutely nothing meaningful about it. Instead of leadership, we get theater. Gov. Spencer Cox folds his arms and calls for a prayer meeting. Lawmakers hand
out turf-removal subsidies and brag about water-wise landscaping while ignoring the massive agricultural diversions that are actually killing the lake. It’s all optics. Symbolism. Sacred sprinkler systems.
The state throws out token legislation— like House Bill 33, for “voluntary” irrigation improvements, and House Bill 410 to let people donate water rights if they feel like it. A Great Salt Lake “commissioner” was appointed to … issue reports and make recommendations.
What we haven’t seen? Mandatory agricultural reductions. Water right buybacks. Strong safe-yield enforcement. Real teeth. Why not? Because Utah’s leaders are more worried about upsetting donors, developers and church-owned farmland than protecting public health or ecosystems. It’s easier to hold a press conference and ask for divine intervention than it is to pass a law that might inconvenience someone with a large checkbook.
And let’s not pretend this is just a water management problem. This is climate change, full stop. The lake isn’t vanishing on its own—rising temperatures, shrink-
ing snowpack and longer drought cycles are speeding the collapse. But in Utah, climate change is still treated like a liberal hoax, and any mention of it triggers eyerolls from elected officials more comfortable quoting scripture than scientists.
Meanwhile, the exposed lakebed sends arsenic-laced dust into communities up and down the Wasatch Front. Migratory bird populations are crashing. Brine shrimp industries are collapsing. And the lake’s elevation keeps dropping toward the point of no return.
This isn’t a mystery. The science is clear, the solutions exist. Other states— like Nevada—are already buying back water rights and retiring them. We just don’t have the political courage here to do what needs to be done.
Because here in Utah, we’ve perfected the art of doing nothing while feeling good about it. We moralize inaction. We pray instead of act, and we call it the “Utah Way.”
This didn’t happen overnight. It’s been built—vote by vote, denial by denial, donation by donation. And unless the people of this state stop choosing leaders who spe-

cialize in spiritual pageantry over policy, the Great Salt Lake will die. And we’ll all pretend it was God’s will, not our failure.
BILL THURMAN Millcreek
We have a president who delights in sounding manly and tough (even though his nickname, TACO, often applies). So when he threatens (belatedly) to apply rigorous sanctions to Russia, or to penalize Mexico for allowing fentanyl shipments across the border, it’s worth remembering that two weeks into his administration, his Justice Department announced that the special interagency task force named KleptoCapture was to be disbanded.
What was the purpose of this agency? To combat financial systems that allow Kremlin oligarchs and allies to conceal their wealth and drug cartels to launder the proceeds of their operations!
Oops (yet again).
RICHARD MIDDLETON Salt Lake City
What is the rudest comment someone made to you?
Christa Zaro
“Do you even work out?”
Sofia Cifuentes
I wouldn’t repeat those words, especially knowing that they came from someone whose intention was to hurt.
I remember one phone call that I answered from someone who was claiming to be a constituent, during the time that I served as a congressional office intern in Washington, DC. Their comment is not printable, alas ...
Paula Saltas
Them: “You’re obtuse with a petulant attitude and you do not belong in customer service and I’d like your supervisor’s number.”
Me: “Sure, here’s my husband’s cell phone number.”
I wrote myself up and put it in my employee file since I was/am the Human Resources person. One year later, their wife wanted a job in our editorial department. Hard pass.
Benjamin Wood
I’ve been called every name in the book by the “fake news” trolls. But I’ll never forget how a certain charter school administrator went around telling parents to disregard my reporting because I was “sleeping with a Democrat.”

BY JOHN SALTAS
Like most kids in Bingham Canyon, I wasn’t born there. Lacking a medical center and pretty much past the era of midwifery home births, a good many of us were born at the Cottonwood Maternity Hospital in Murray. What remains of that facility—originally established in 1924 by the LDS Murray Stake Relief Society—sits just a few blocks east of State Street on 5600 South.
My mother often drove past and recalled the events of that blessed and most important day of her 96-year life. Lacking their own, my parents borrowed a car from Tom Angelos—an old Greek bachelor who lived in a wobbly shack up on the hill in Lead Mine—in order to get to the maternity hospital. My mother’s aunt worked there and helped me say hello to the world and, thus, to Murray first.
I’ve always liked Murray, situated as it is in the center of the valley, easy to get to either the west-side homes of my family or into Salt Lake City where I worked, and where in my youth, I attended college while learning the finer arts of smoking, drinking and disco dancing. They didn’t call me John Revolting for nothing.
I live in Murray and our subdivision is like any other. Our neighbors who know each other mostly met due to having kids of the same age, playing in the same sports leagues, catching the same buses or being carpooled to school by parents trading off those duties. It’s Utah, so ward folk know ward folk. The rest barely know each other, including the ward folk. Ahh, life in suburbia.
In Bingham Canyon (my corner was Lead Mine) every-
one knew everyone and most of us lived in wooden homes. Our Murray brick homes aren’t stacked on one another upon dry hillsides, and each home has a lawn. All of the lawns in Lead Mine, combined, would not have equaled just one average lawn in my Murray neighborhood.
The dominant flowers in Lead Mine, if there were flowers at all, were roses, lilies, irises, occasional hollyhocks and the sunflowers that grew everywhere. Sunflowers are not as revered down here.
I think they’re pretty—always have, always will, so each time I pedal my bike around, as I do most evenings, I make a point of admiring the rare homes that have a sunflower or two basking as they are wont to do. I’m sure I’d like the people inside in each case, but alas, I don’t know most of them.
I’ve been riding my bike through my subdivision for about 15 years, just round and round, accumulating thousands of miles in so doing but, painfully, accumulating few new real friends. Life in suburbia just isn’t conducive to making pals and as the saying going, fences make good neighbors. We have lots of fences in our neighborhood.
During COVID, things changed. I formerly had the streets nearly to myself, but when the virus struck, more people began spending time in their yards and a fair number started their own walking rituals. Waving and nodding at each other ensued, and in time—maybe two or three years later—I began to ably match a walker to a specific home. Curiously, the Venn diagram of new walkers and dog owners nearly completely overlaps these days, the single positive outcome of COVID.
I can now identify the occupants of perhaps 20 of the 60-or-so homes in the neighborhood in which I’ve lived for nearly 30 years. And that’s pretty good, but I knew everyone in Lead Mine.
The only people I’m confident who know more fellow neighbors than myself are the LDS Bishops—both of whom I consider to be among my best neighbors.
Our neighborhood is ethnically and religiously diverse—very similar to Lead Mine—and my House rep and senator are both Democrats. I miss that my Murray neighborhood doesn’t have a walkable barbershop, a bar, gas station or café. All of us basically just drive in and out of our garages via roads upon which Murray City, for some reason, recently decided needed to be resurfaced. Bad call, Murray.
There were two notable bulldozer operators working in the Bingham Canyon mine when I was young—Don Nepolis (my uncle) and Yobo Borich, both of whom could dozer a smooth roadway out of any pile of muck, mud or mountainside. After the recent resurface of our Murray subdivision, I’m convinced that the art of road building and road repair is not a Murray City priority. I’m also convinced Yobo and Uncle Don—in their dozers—could have smooth-shamed whoever produced this hot mess.
I’ve safely biked and walked basically the distance from here to Chicago along these streets. Now it’s a nightly survival test. There are mid-street uplifts that resemble overlapping continental shelves or Wasatch Front fault lines, pockmarks left behind from some roadway smallpox and random mounds of crap that just beg to trip a passerby. City streets shouldn’t double as an obstacle course. It’s only a matter of time before a kid faceplants while on a scooter, skateboard or a pair of roller skates. Water grates were blocked, at least one soda can was flattened into the surface, and drains were plugged. Other segments were fully missed. It appears that some road mix of sticky black paint and pebbles (which now flake off making bike turns a tad tricky) were sprayed through a broken spigot, then flattened with a giant, dull yard rake. I’m having Syncrete flashbacks.
Yobo and Uncle Don could have done a better job with bulldozers. If they were still around, I’d sic ‘em on the new Murray City complex. See how they like it. CW Send comments to john@cityweekly.net




BY KATHARINE BIELE | @kathybiele BY CAT PALMER
Wow, two weeks in a row! Lt. Gov. Deidre Henderson gets another round of kudos for doing her … well, her job. Last week, she held off Utah County’s “fast cast voting,” an untested idea to discourage mailed-in ballots. This week, she held off the Justice Department, which for reasons that can only be attributed to conspiracy theories has targeted this great, red state for its voter rolls. Utah is among 15 states— five of which are majority Republican—that are the subject of a search for voter fraud and non-citizen voting. And if you’re wondering, yes, this has to do with the “stolen” 2020 presidential election, among other fantasies. Of course, the Trump administration is also worried about the upcoming 2026 election. “The unusually expansive outreach has raised alarm among some election officials because states have the constitutional authority to run elections and federal law protects the sharing of individual data with the government,” the Associated Press wrote. Be sure your voting information is marked private.
No one knows how much destruction it will take before politicians acknowledge that “climate change” is real. There’s so much going on that we’re discovering new meteorological terms such as “rain bombs, heat domes, atmospheric rivers, weather whiplash, and polar vortexes,” wrote Dr. Mark Goldfarb of the Utah Physicians for a Healthy Environment. Here in Utah, our governor has just declared an emergency over the fires raging in and around the state. The Grand Canyon and Utah fires are even creating their own weather systems with the huge fire clouds that they produce. So far, Utahns don’t have to breathe the kind of fire-borne toxic air that has engulfed Chicago, but this too could be coming. It seems that rather than give up fossil fuels, the only embrace of alternative energy is nuclear because, according to the president, wind turbines will kill us.
You can’t expect an 18-year-old boy to understand consent, can you? After all, what’s a little sex between two people—as long as they’re not gay? Here in Utah, girls 14 and older can consent to a little fun, no matter what the outcome. In the most recent case, an 18-year-old relative of Senate President Stuart Adams, R-Layton, reportedly got a sweetheart deal from a judge because Adams managed to change the law, allowing for lesser charges. But he and the other Utah lawmakers who made it happen insist that the law wasn’t retroactive and had nothing to do with the “serious mistake” the boy had made. The judge didn’t specifically use the new law, but nonetheless gave deference to the boy, who would have been charged with child rape and child sodomy, all first-degree felonies. Now, he gets basically a slap on the wrist. Boys will be boys and girls—well, they should be locked up until they’re old enough to consent. CW
Salt Lake City is a little dimmer now that The Garage on Beck has closed its doors. Tucked away on the industrial stretch of Beck Street, this unassuming roadhouse wasn’t just a bar—it was a heartbeat.
It was a place where community and music collided, where Sunday brunch could melt into an evening set on the patio, and where the smell of fried funeral potato bites was practically a spiritual experience.
For years, The Garage was where we went to feel like ourselves. Summer afternoons drifted into nights under the twinkle lights, cold drinks in hand, laughter echoing over the sound of guitars and fiddles. Monday nights were sacred—Triggers and Slips lit up the stage with heart and grit, and you just knew you were exactly where you were supposed to be.
This was a tiny-but-mighty stage that welcomed legends and locals alike—where Rick Gerber, Michelle Moonshine, Morgan Snow, Jim Bone & The Dig and Pepper Rose shared the mic with Pixie & The Partygrass Boys, Kate MacLeod, and Turtle Dovin’. We can’t forget Harry Lee & the Back Alley Blues Band, Nathan Spenser, Branson Anderson, Courtney Lane, Talia Keys, Daniel Young and Sarah DeGraw, to name just a few.
The stage was a launchpad, a place where talent met soul under the Salt Lake sky. On any given night, you might catch the heartfelt harmonies of The Proper Way, the humor and grit of Two Old Guys or the rowdy energy of Folk Hogan shaking the walls. J-Rad Cooley brought his signature swagger, while Carl Carbonell and Muskrat Jones delivered storytelling with a bluesy pulse. J.T. Draper, George Nelson III, and Kelly Bellerose each brought raw emotion and beauty to their sets, their timeless voices often lingering long after the amps cooled.
These artists (and many more) didn’t just play the Garage—they helped build its legacy. We danced to tribute nights honoring Tom Petty and David Bowie. We raised glasses to the blues of Tony Holiday and the unmistakable soul of Joe McQueen. The Garage wasn’t just a venue—it was a vibe. Even after it caught fire (twice) it rose back up, rebuilt by the people who believed in it.
The Garage on Beck never left its people hanging—not even on the holidays. When the world felt quiet or lonely, they flung their doors open on Christmas Day, offering a warm seat, a Chinese food buffet and a whole lot of love. The Garage didn’t just serve food and drinks—it served connection, joy and a damn good reason to show up.
And behind all of that were the people who made it happen. Angelique, Marsha, Bob—your care and vision created something sacred. To the staff (and sound engineers) who served up smiles and hot plates, who made sure the drinks were cold and the nights were smooth—you were part of something bigger, and we thank you.
Summers won’t be the same without The Garage. But the stories, the friendships, the music—we carry all of that with us. CW









Upon the return of King of the Hill, here are more Fox animated series that deserve another shot.
BY BILL FROST comments@cityweekly.net
After 16 years away, the beloved 1997–2009 Fox animated series King of the Hill has returned, in streaming form, on Hulu. The recent comeback of show creator Mike Judge’s other classic cartoon, Beavis and Butt-Head, was a minor hit for Paramount+, so why not? (Note to Mike: Do not attempt a remake of Idiocracy—you can’t top our current reality.)
There are plenty more former Fox and Fox-adjacent animated series worth reviving; here are but a few.
Axe Cop (2013–2015; Prime Video, YouTube): Comic book writer/artist Ethan Nicolle took the out-there ideas of his 5-year-old brother Malachai and turned them into cartoon gold with Axe Cop (catch phrase: “I’ll chop your head off!”).
In the eventual Fox/FXX TV series, Axe Cop was brought to hilarious life with the voice of Nick Offerman, who delivers both unhinged murderous gusto and childlike whimsy over 22 11-minute episodes. Fox should cancel the craptacular Krapopolis and reinstate Axe Cop ASAP.
Bordertown (2016; Hulu): It didn’t get a fair shake during its original Fox run, but we need Bordertown now more than ever in these ICE-y times. The co-creation of cartoonist Lalo Alcaraz (La Cucaracha) and writer Mark Hentemann (Family Guy) follows Mexifornia border patrol officer Bud (voiced by Hank Azaria) and his next-door frenemy Ernesto (Nicholas Gonzalez) as they navigate an increasingly-brown America. Fox & Friends would hate Bordertown—which is all the more reason to bring it back.
High School USA! (2013–2015; Prime Video, YouTube): Writer Dino Stamatopoulos was already a fringe hero thanks to his work on Mr. Show, Late Night with Conan O’Brien and the darkest Adult Swim series of all time, Moral Orel, but his short-lived High School USA! pushed the taste limits of Fox and FXX. On the surface, it’s Archie Comics with the sex, drugs, and more sex quotient cranked to overdrive, but underneath … yeah, it’s just horndog Archie + Betty + Veronica fan fiction. For discerning sickos only.
Major Lazer (2014-2015; Prime Video, Fandango at Home): Speaking of drugs, Major Lazer was designed with altered states in mind. The single-season series is based on DJ/producer Diplo’s EDM collective of the same name, animated in the style of ’80s G.I. Joe cartoons, and headlined by Jamaican superhero Major Lazer (voiced by Adewale Akinnuoye-Agbaje of Oz and Lost). Each 10-minute episode features slam-bang action and killer music, as well as guest voices like Charli XCX (nine whole years before Brat Summer).
Little Demon (2022; Prime Video, YouTube): The TV morality police really, really, really hated Little Demon, which inadvertently amplified the show more than FXX ever did. The series stars Danny DeVito as the voice of Satan, Lucy DeVito (the IRL daughter of Danny and Rhea Perlman) as the teen Antichrist and Aubrey Plaza as her human mom/regretful one-night Beelzebub stand. Despite the demonic overtones and frequent gore, Little Demon is a sweet-ish family story that deserves another season. Dicktown (2020–2022; Hulu): It’s not officially canceled, but Dicktown hasn’t dropped a new episode since 2022, so it’s ripe for a comeback. John Hunchman (voiced by John Hodgman) is an exchild actor who starred in an Encyclopedia Brown-esque TV show, but now he solves local crimes as an adult in his hometown of Richardsville (aka “Dicktown”). Even sadder, his detective partner is his former childhood bully (David Rees, Hodgman’s co-writer). Think of Dicktown as the cartoon flipside of Poker Face.
Lucas Bros. Moving Co. (2013–2015; Prime Video, YouTube): The stoner-core comedy of twins Keith and Kenny Lucas usually only works in small doses (or tokes) in live-action fare, but their semi-autobiographical Lucas Bros. Moving Co. animated series may be their ultimate vehicle. The pair summarizes their show as “Bill & Ted plus Workaholics plus The Wire (minus the bleakness),” but the lackadaisical pacing has more in common with another of their influences, The Life & Times of Tim (if you know, you know).
The Great North (2021–2025; Hulu): Like Dicktown and Little Demon, Fox Animation Domination staple The Great North hasn’t been technically canceled, but it’s nowhere to be found on the network’s upcoming 2025–2026 schedule—almost always a sign to expect the worst. The series wasn’t worth such concern at first, when it came across as just a Bob’s Burgers in Alaska knockoff, but The Great North has since evolved into a quirky series equal to its cartoon cousin. Again, take Krapopolis first, Fox. CW
Complete listings online at cityweekly.net
Bill Engvall @ Wiseguys West Jordan
It’s not exactly a brand-new phenomenon to have performing artists—whether musicians or comedians—go on a “farewell tour,” only to have second thoughts about hanging up their spurs.
Comedian Bill Engvall notably said goodbye to touring in 2022 with a New Year’s Eve show at Salt Lake City’s Eccles Theater, and settled down in Park City, only to realize that maybe he still had some work to do.
“I missed it. I missed the performances. And you can only play so much golf,” Engvall told the Palm Springs Desert Sun back in February. “In hindsight, I should have just taken a break instead of making a big announcement. I don’t think anybody would have known the difference.”
It’s likely plenty of fans are happy to have Engvall back on stages, as he built up plenty of goodwill over the years, from the Blue Collar Comedy Tour of the early 2000s with Larry the Cable Guy, Jeff Foxworthy and Ron White, to his three-season self-titled TBS sitcom later that same decade. His folksy humor and way of poking fun at the frustrating people we all encounter—often using his trademark “here’s your sign” catchphrase—are still welcome, and he promises to play the hits.
Bill Engvall visits Wiseguys West Jordan (3763 W. Center Park Dr.) for three shows, Aug. 7 @ 7 p.m. and Aug 8 – 9 @ 6:30 p.m. The Saturday show is sold out at press time, and tickets for the others are going fast. Visit wiseguyscomedy.com for tickets and additional event information. (Scott Renshaw)












Let’s face it: Not all of us have that spark that turns people into creators. But for those who do have such a spark, it has in many ways become easier than ever to share that spark with the rest of the world. From online platforms like Etsy to craft marketplaces, amateur and small-scale makers are now able to turn their avocations into a little cash and a lot of appreciation from those who want to support that creative instinct. And locally, no occasion is more devoted to this principle than the annual Craft Lake City DIY Festival.

For three days, more than 500 artisans—sharing ceramics, fine art, textiles, jewelry, woodwork, food and more—will be displaying their work for guests ready to check out all the creative talent Utah has to offer. The dedicated Kid Row even presents stuff from young creators to help support that creative drive. A STEM exhibition celebrates technological creation, and visitors can try their own hand at creating with the DIY area. And in the midst of it all you can enjoy performances by more than 40 artists presenting live music, DJ sets, cultural offerings, dance and more.
The 2025 Craft Lake City DIY Festival comes to the Utah State Fairpark (155 N. 1000 West) on Friday, Aug. 8 (5 p.m. – 10 p.m.), Saturday, Aug. 9 (noon – 10 p.m.) and Sunday, Aug. 10 (noon – 6 p.m.). General admission tickets are $13 online in advance, $15 on-site; children 12 & under are free. Additional charge is required for those bringing dogs. Visit craftlakecity.com/diy-festival for tickets and additional event information. (SR)

It’s been nearly 50 years since the musical Annie debuted on Broadway, and in the intervening decades, it’s become a family-friendly standard for theater companies both around the country and the world. But that can make it easy to forget the circumstances in which it was born, and the improbable way in which lyricist Martin Charnin, composer Charles Strouse and writer Thomas Meehan concocted a story out of the popular Little Orphan Annie comic strip that launched in the 1920s. Into the downbeat-post Vietnam era and a particularly gritty time for New York City, the tale of a plucky, optimistic orphan getting a chance at happiness emerged to become one of the longest-running shows of its time.
Of course, it certainly helps that Annie boasts some of the catchiest songs of the modern musical-theater canon. While Annie’s trademark anthem “Tomorrow” became a staple of kids’ talent show performances for generations, there’s also great material like “I Think I’m Gonna Like It Here,” “It’s a Hard-Knock Life,” “Easy Street,” “You’re Never Fully Dressed Without a Smile” and “Maybe.” You can get a chance to hear all of those classics and more when a cast of talented locals—including talented young performers—present in Salt Lake City this month.
Wasatch Theatre Company’s production of Annie comes to the Regent Street Black Box (144 Regent St., adjacent to the Eccles Theater) for five performances only: Aug. 11, 14 & 15 @ 7 p.m., and Aug. 16 @ 1:30 p.m. & 7 p.m. Tickets are $25; visit saltlakecountyarts.org to purchase tickets. (SR)
The legacy of untimely passings drives three new theatrical releases.
BY SCOTT RENSHAW scottr@cityweekly.net @scottrenshaw
The “horror film that’s about Trauma, actually” has become such a trope that it’s genuinely impressive when a filmmaker finds a fresh way to approach it, and that’s what writer/director Seth Worley accomplishes in this entertainingly weird piece of kid-friendly monster fare. It centers around the Wyatt family—recently-widowed dad Taylor (Tony Hale) and his two kids, Amber (Bianca Belle) and Jack (Kue Lawrence)—who are dealing with their grief in very different ways. For Amber, that includes drawing a variety of menacing creatures in her notebook, which subsequently come to life when they fall into a magical pond. Worley benefits from some great casting, including the appealing kid actors, Hale and D’Arcy Carden (as the kids’ aunt), but the actors themselves benefit from a sharp, funny script full of laugh-out-loud moments. But it’s hard to overstate the wonderful imagination involved in the creation of Sketch’s rampaging beasts, which somehow manage to be both terrifying and hilarious, like a massive beast that vomits glitter, or skittering “eye-ders” that disappear in a puff of chalk dust when crushed. It’s ultimately hard to escape the fundamental familiarity of the psychological arc, though even that is mixed up with unsettling hints of Pet Sematary. You just don’t often get so much genuine creativity in PG-rated movies, and managing to do so while turning The Babadook into a matinee treat. Available Aug. 6 in theaters. (PG)
The “tragic artist” bio-documentary is its own entire subgenre at this point, so it feels like filmmakers need to be putting in greater effort in order to inspire a response more substantial than, “Huh.” Unquestionably, it was a tremendous loss when Buckley—a singer-songwriter with an angelic voice and matinee-idol looks—drowned in 1997 at the age of 30, with his acclaimed debut album Grace his only

recording. Director Amy Berg certainly provides a comprehensive character study, exploring his childhood with a single mother, his discomfort at comparisons to his biological father, musician Timothy Buckley; and his struggles with fame, likely intensified by undiagnosed mental health issues. The film benefits from energetic animations as part of the visual palette, amazing access to archival and personal material like phone voice messages to his mother, lovers and friends, plus great anecdotes like the time Buckley climbed a stage structure to get a better view of one of his idols, Robert Plant. Yet somehow, Buckley remains just as enigmatic at the end of the movie as he was at the beginning, with the material never pulling together in a more substantial way than a reasonably-accomplished VH1 Behind the Music installment. If your creative choice when reaching the time of Buckley’s passing is to play his celebrated cover version of Leonard Cohen’s “Hallelujah,” you’re just not trying very hard to break free from the obvious. Available Aug. 8 at Broadway Centre Cinemas. (NR)
Director/co-writer/star Kristin Scott Thomas clearly has some personal issues she’s working through, and it would have served this comedy-drama better if there had been more to it than the sense of working through personal issues. Thomas plays Diana, the matriarch of a family of three daughters—Royal Navy captain Katherine (Scarlett Johansson), actress Victoria (Sienna Miller) and nurse Georgina (Emily Beecham)—who all gather for Diana’s wedding to her third husband, as the sisters all still deal with unresolved feelings about their fathers/Diana’s previous two husbands, both of whom died in military service. Thomas comes up with one particularly effective device in turning Katherine’s flashbacks of her father and stepfather into sketchy animations (directed by Reza Riahi) in which eyeless faces render the men as abstractions. Unfortunately, that’s one of the few places where the narrative doesn’t feel thin and superficial, with all of the sisters’ relationship drama—Victoria’s flirtation with a childhood sweetheart; Katherine’s unwillingness to marry her long-time partner (Freida Pinto); Georgina’s unfaithful husband—packed into too-tidy confrontations set to Rolfe Kent’s whimsical strings. Even the wedding itself feels rushed, as though everyone had somewhere they really needed to be very quickly. Thomas (co-writing with her own real-life partner, John Micklethwait) gives herself the big speech about needing to move on from childhood grief, but this bit of catharsis might end up working solely for her. Available Aug. 8 in theaters. (NR) CW





















Man claims Sandy landlord ignored the mold that was damaging his health.
BY SYDNEE CHAPMAN comments@cityweekly.net
The following story was reported by The Utah Investigative Journalism Project in partnership with Salt Lake City Weekly
Jonathan Rodriguez started noticing small issues after moving into the Legends at River Oaks apartment complex in Sandy: a musty smell; a bit of mold in the toilet; and the fact that his cat, Toby, went from a usually friendly feline to one constantly hiding under the bed.
Then a few months into his nine-month lease, Rodriguez said, he started getting sick. His eyes would water, he couldn’t taste anything and couldn’t breathe properly. He started taking COVID tests, but each one came back negative.
“It just kept happening over and over, and I remember I’d come home at night and all of a sudden just couldn’t breathe,” he recalled.
Later, Rodriguez found what he described as a wet, starfish-sized growth on the wall behind his TV. He also noticed black-colored mold along the bottom of the wall.
Photos Rodriguez shared with The Utah Investigative Journalism Project match those descriptions. When Rodriguez pulled up the carpet, he said it was wet underneath.
“Immediately, I’m like, ‘This explains it. This is why I’ve been sick for months and I couldn’t breathe and all this other stuff,’” he related.
Rodriguez said he immediately called the property’s maintenance but stated that they failed to remediate the problem, which he said was attributed to the water heater not draining properly.
When Rodriguez pushed the issue, he said the property management team pointed to a mold clause in his lease stating that residents indemnify the landlord of any liability relating to mold, mildew or other contaminants, “regardless of the source.”
Under the lease, residents aren’t allowed to hire out or DIY any testing for contamination, but can request the owner do so if the resident prepays for it. The results, the lease continues, are property of the building owner, who is only obligated to disclose positive results exceeding legal limits.
“They basically did not care,” Rodriguez said. “They did not want to help me whatsoever. They didn’t want to send anyone in there professionally … It was really like, ‘Sorry, you signed something. Bye.’”
Legal experts say that tenants have limited options if a landlord refuses to address hazards like mold.
The complex isn’t the only one using such mold clauses; yet, Utah law also requires landlords to maintain sanitary and safe conditions.
An investigation by the UIJP found that Rodriguez was not the only former tenant of Legends at River Oaks, or its parent company Weidner Apartment Homes, to have experienced mold problems. But the law around tenants’ options and protections in these situations can be limited, say legal experts.
Tenants may, however, have some options under the Utah Fit Premises Act, a law governing rental unit standards.
Legends at River Oaks referred the UIJP to Weidner Apartment Homes, which said over the phone that its spokesperson would be in contact with a reporter. The spokesperson did not reach out, nor did the company respond to a message through the contact form on its website.
The Salt Lake County Health Department doesn’t regulate mold since it’s an allergen and there isn’t a “safe” level of mold established by the department or other health organizations like the Centers for Disease Control and Prevention (CDC). Because of this, neither the Health Department nor the CDC recommend mold testing.
“There’s not a place that you can go that doesn’t have mold. It’s in the world around us,” said Karla Bartholomew, an environmental health scientist with the department.
The CDC states that exposure to damp and moldy environments can cause a variety of health effects, or none at all.
“Mold is not infectious. Mold isn’t a major health concern,” Health Department spokesperson Nicholas Rupp said. “So for people who are allergic to mold, it can result in some allergy-like symptoms, kind of like hay fever or seasonal allergies. But for people
who aren’t allergic, who aren’t susceptible to those allergens, it doesn’t cause anything.”
Bartholomew said if tenants experience allergy symptoms related to mold, they should speak with a medical provider.
Although the department doesn’t regulate mold, it does still respond to complaints related to active water leaks, flooding and sewer problems. In Bartholomew’s 15 years as a Health Department inspector, she said having a conversation with a landlord fixes the problem 80% of the time.
If a landlord isn’t being responsive, the department then issues a warning letter. Tenants should check their leases, however, for Bartholomew pointed out that while the department can force a landlord to repair something, the landlord can still pass the cost on to tenants.
For mold problems, Bartholomew recommends avoiding humidifiers and regularly cleaning areas with frequent moisture, like bathrooms.
Tenants’ legal options are also limited. The Utah Fit Premises Act requires landlords to maintain units and “to protect the physical health and safety of the ordinary renter.”
The act offers renters two remedies if landlords fail to meet those standards: repair and deduct; or rent abatement.
The first option allows renters to pay for the repair up front and then deduct the cost from future rent.
Tenants can deduct up to two months of rent and must give receipts to the landlord. This option may not be plausible if the repairs are more expensive, if the tenant doesn’t have the money to pay for repairs, or if a lease restricts how and what a tenant can repair.
The second option, rent abatement, does not mean withholding rent. In fact, doing so isn’t permissible under Utah law.
Instead, this option allows tenants to terminate their lease early. Tenants first put the landlord on
“The entire [Fit Premises] act should be redone and considered in a way that is more equal to the rights of our tenants in Utah.”
—Brooke Byall

notice to repair the problem within 24 hours, three days or 10 days, depending on the severity of the problem. If the landlord doesn’t make substantial steps toward repairs in that time, the tenant can then terminate the lease agreement and has 10 calendar days after the repair window ends to move out.
The landlord is then required to refund their entire security deposit and any prepaid rent. If a landlord ignores that requirement, the tenant can sue them in small claims court.
Tenants must be fully in compliance with their lease to use the act. Even something as simple as having a barbecue on your porch when the lease prohibits this can cause issues later on.
But legal experts say pursuing those remedies can be risky for tenants and instead recommend first trying to negotiate with landlords.
“The landlord will likely be looking for any easy way out of it or to get even with you,” noted Denise George, a licensed paralegal practitioner. “You need to be very prepared for what all the different options are. And I’ve never yet seen anybody be able to put it all the way through.”
George suggested that any renter considering using the act should first speak with a legal professional. She also recommended that tenants first try to negotiate with a landlord before going to the Fit Premises Act. Doing so, she said, is often a lowerrisk option, especially for renters who don’t have the desire or resources to move out of their apartment.
“There are downsides to the tenant for using the Fit Premises Act as well because the landlord could decide just to not make any repairs and give you 10 days to move out of the residence,” George said. “It’s a protection that we have for tenants, but it’s not a great one … It’s written to protect the landlords a lot, and it is vague and a little confusing to use.”
The act doesn’t specifically mention mold, and legal professionals disagree about whether it’s a good option in those cases.
Jonathan Rodriguez holds up an at-home mold testing kit in his former unit at Legends at River Oaks apartment complex in Sandy.
Brooke Byall, a licensed paralegal, argued that mold does fall under the act.
“A landlord has an obligation to provide a clean and safe environment that is habitable. Mold can cause a premises to be uninhabitable,” she contended in an email.
Utah Legal Services Director of Litigation Jacob Kent disagreed, saying that the act is better suited to address the root causes of mold, like a leak or flooding, rather than the mold itself.
Both George and Byall stressed that the act needs significant changes to make it fairer to tenants, including clarifying its language, requiring landlords to house a tenant while they make repairs and putting the bigger burden of evidence on the landlord.
“The entire act should be redone and considered in a way that is more equal to the rights of our tenants in Utah,” Byall stated.
Legends at River Oaks apartment complex in Sandy is surrounded by well-maintained landscaping and scores of covered parking spots. The property is dotted with walking paths, a dog park, playground and swimming pools.
But former tenant Natalia—who asked to be identified by only her first name out of fear of retaliation—says her own experience with mold and what she observed from neighboring units led her to believe the place had issues hiding behind fresh coats of paint and modern appliances.
“It kind of feels like they’re just sort of biding their time until they have serious, serious issues,” she said.
Natalia was only allowed to tour the model unit before moving in and said her actual unit had bulging or tilted walls, ceilings and floors as well as mold in the bathroom.
During Natalia’s 21 months in the apartment, she
said two neighbors appeared to have water issues, including one instance when water from the above unit leaked out near Natalia’s front door.
Maintenance workers came out to address the mold in her bathroom, but the issue persisted, she said. By that point, she was near the end of the lease. She remarked that it’s hard to keep fighting with management when it “feels like it’s going to take more energy than it’s worth.”
One former Weidner tenant, however, did put in the energy. Lori Munoz, who lived at a Weidner property in Texas, sued the company in 2023, claiming that her health issues were linked to mold, toxins and water damage that the company refused to properly address, according to court documents.
The conditions and contamination became so bad, Munoz alleged, that she was forced to abandon all her belongings. Munoz’s case ended in a settlement last fall.
“Every single day, while she was in her apartment, Lori wheezed, coughed and had difficulty seeing because of a film that covered her eyes,” a legal complaint in the case reads. “Her nose bled all of the time, she could not sleep, and would often wake up and felt like she was choking.”
Emilie Minshew, a 29-year-old Utah native who lived at Legends at River Oaks from Spring 2018 to Spring 2019, also experienced mold issues.
It wasn’t until the last few months of her and her husband’s lease that the couple discovered a large mold patch in their bedroom behind a dresser. Minshew had been sick multiple times since moving into the unit and recalled how she began to put two and two together.
“I couldn’t figure out why I kept catching pneumonia and feeling gross and cruddy,” she said. “I have asthma, but it’s usually really well managed. At that point in my life, I wasn’t even on a daily medication or anything.”
Minshew called maintenance a handful of times about the mold, unsuccessfully.
“They canceled every time we called, and then they blamed it on us,” Minshew said, adding that the excuses ranged from claiming she had asked to cancel the work request to saying maintenance couldn’t come in because the couple had a dog. “We had a Corgi puppy who was in a crate out of the way—just kind of like weird excuses trying to put it back on us.”
Rodriguez eventually took matters into his own hands and bought a mold-testing kit at Home Depot. The test results, which he shared with the UIJP, were positive for a handful of common mold and fungi. Not all the species and strains of those identified are dangerous, but some can cause serious illness, particularly for individuals with existing respiratory issues or mold allergies.
Rodriguez’s doctor eventually diagnosed him with an allergy to mold spores. “He should only go back in with a mask on to collect his personal items,” reads a copy of the doctor’s notes that Rodriguez shared with the UIJP.
By that point, Rodriguez only had a few days left in his lease, but he says the ordeal has stuck with him even a year later.
His goal in sharing his experience, he stressed, is to raise awareness about tenants’ rights when it comes to mold.
“It was just kind of haunting me after a while,” he said, adding that he still can’t taste or smell as well as he used to. “I’ll have issues where I can’t catch my breath because I was living in this space as this thing was growing for so long.” CW









Millcreek’s Burgers By Guayoyo takes diners on a world tour.
BY ALEX SPRINGER comments@cityweekly.net @captainspringer
One of the upsides of fast-food burgers becoming more expensive is that it’s harder to compromise your standards. When you depart from the value menu at your local fast-food burger vendor, you start to see cheaply-made items that are retailing anywhere from $8 - $12. With that in mind, it makes more sense to explore Utah’s own restaurants where you can rediscover a love for locally-made burgers.
If that sounds up your alley, then you’ll want to check out Burgers By Guayoyo
This recently-opened Millcreek restaurant has been blowing up on social media (@burgersbyguayoyo) for bodaciously huge burgers dripping with melty cheese, creamy avocado and other diverse toppings. The mission of Burgers By Guayoyo is to encapsulate an international cuisine in one burger, and its menu is filled with options that will delight the culinary travel enthusiast.
Every burger on the Guayoyo menu seeks to tell its own story about the cuisine in reference. Some of the combos work a little better than others, but the creativity that is on display throughout this menu is impressive. Regardless of what you order, the Guayoyo team will put their heart and soul into it—each burger is gorgeously constructed and plated on banana leaves or nori, depending on where your journey takes you.
A good example of Guayoyo’s concept is La Capo ($12.85) and its nod to Italian
flavors like roasted bell peppers, truffle pesto, marinara and balsamic glaze. Each sizable burger comes with some kind of thematic surprise from the chefs—in this case it’s a patty-sized round of fried provolone cheese that dramatically goops out once you bite into it. La Capo’s towering silhouette is a good indicator of how spatially large these burgers are, both in height and width.
I also liked La Tokio ($12.55), which incorporates incredibly savory Japanese flavors like miso aioli and tare sauce, commonly used in sushi recipes to add a rich kick of umami. It also includes a Japanese slaw made from shredded carrots and daikon for some acid, and there’s some sliced avocado, arugula and aged cheddar cheese for good measure. I’ve had enough stacked burgers to know that no matter how many bells and whistles are attached, the strength of a burger always comes down to its protein. In the case of La Tokio, the burger patty was excellent—juicy, flavorful and packed with layers of savory goodness thanks to that tare sauce.
There is but one chicken sandwich amid all the beef patties and pork belly that are on display at Guayoyo, and it’s known as La Malaya ($11.75). It’s a tremendous addition to the local fried chicken sandwich scene as it’s got a gigantic katsufried chicken breast as its focal point. The breading on this rivals that of your favorite Hawaiian grill, and the Japanese mayo, marinated cucumbers, soy caramelized onions and cheddar cheese send it over the top. It’s an excellent option for those who are opting for something other than a burger.
Though these opulent burgers are full meals in and of themselves, the side menu at Guayoyo presents a nice complement to its main dishes. They’re probably best shared since you do get a good portion of each; my wife and I visited, and we found that a burger apiece plus a basket of fries ($4.95) to share was the best option.
As for sides that could double as centerpieces, you’ve got the Nachos Guayoyo ($12.95), which loads up a plate of tortilla chips with chorizo, ground beef, spicy cheddar, guac and pickled onions.
The Guayoyo specialty fries ($6.50) are also big enough to be their own meal, and they too adopt Guayoyo’s international travel narrative. These fries come in huge baskets that represent America, Asia, Mexico and Italy, with toppings that evoke each destination. I could see getting one of these if you and your dining companions are truly famished—just remember to pace yourself out there, because Guayoyo also serves gigantic milkshakes ($5.45) for dessert. With this menu of gigantic burgers, shareable sides and high-top milkshakes, you have to pick your battles carefully.
Based on the obvious care that has gone into each burger on the menu, it’s clear that Burgers by Guayoyo is taking its quality seriously. It’s also complemented by a colorful restaurant space with an urban, graffiti-dominated aesthetic that makes for a fun spot to meet up and chow down. I appreciated the service that you get here as well; our server was happy to tell us about every burger on the menu, and the food arrived quickly after we ordered. Based on the composition of the restaurant’s burgers and the effort that went into plating, this was a truly pleasant surprise.
I’m glad that burgers are becoming a destination-worthy menu item again. Their versatility has always been off the charts, and it’s great to see a local restaurant embrace them in the way that Guayoyo does. Anyone who salivates at the prospect of a burger that leaves your hands and forearms dripping with burger fixings will want to pay this place a visit.
























2 Row Brewing
73 West 7200 South, Midvale 2RowBrewing.com
On Tap: “Czech One-Two” Czech Pilsner
Avenues Proper 376 8th Ave, SLC avenuesproper.com
On Tap: Steamy Wonder Rye Steam Ale
Bewilder Brewing
445 S. 400 West, SLC BewilderBrewing.com
On Tap: Pink Boots - Pink Pony Pilz
Bohemian Brewery
94 E. Fort Union Blvd, Midvale BohemianBrewery.com
NEW Releases: Kölsch, Dusseldorfer “Alt” Bier
Bonneville Brewery 1641 N. Main, Tooele BonnevilleBrewery.com
On Tap: Peaches and Cream Ale
Chappell Brewing
2285 S Main Street Salt Lake City, UT 84115 chappell.beer
On Tap: Pie Hole - Strawberry Rhubarb Tart Ale
Corner Brew Pub Sugar House 2110 S. Highland Drive, SLC saltlakebrewingco.com/ wasatch
On Tap: Top of Main Coalition Hellfire Chili Pepper Ale
Craft by Proper 1053 E. 2100 So., SLC properbrewingco.com
On Tap: Steamy Wonder Rye Steam Ale
Desert Edge Brewery
273 Trolley Square, SLC DesertEdgeBrewery.com
On Tap: Centennial Steamer, California Common Lager
Epic Brewing Co. 825 S. State, SLC EpicBrewing.com
On Tap: Chasing Ghosts IPA
Etta Place Cidery
700 W Main St, Torrey www.ettaplacecider.com
On Tap: Velvet Ridge Cider, Rhubarb Peach Wine
Fisher Brewing Co.
320 W. 800 South, SLC FisherBeer.com
On Tap: A rotation of up to 17 Fresh Beers!
Grid City Beer Works
333 W. 2100 South, SLC GridCityBeerWorks.com
On Tap: Cask Nitro CO2
Helper Beer
159 N Main Street, Helper, UT helperbeer.com
Hopkins Brewing Co. 1048 E. 2100 South, SLC HopkinsBrewingCompany.com
On Tap: Aroma Therapy, Double Dry-Hopped Blonde
Kiitos Brewing
608 W. 700 South, SLC KiitosBrewing.com
On Tap: Sake Rice Lager (collab with Tsuki Sake); Tropical Haze IPA
New Launch: Fonio Fusion - 6.6%
Level Crossing Brewing Co. 2496 S. West Temple, South Salt Lake LevelCrossingBrewing.com
On Tap: El Santo Mexican Lager
Level Crossing Brewing Co., POST 550 South 300 West, Suite 100, SLC LevelCrossingBrewing.com
On Tap: Fruit Bat Sour Ale
Moab Brewing 686 S. Main, Moab TheMoabBrewery.com
On Tap: “Big Drop” West Coast Pilsner
Mountain West Cider
425 N. 400 West, SLC MountainWestCider.com
On Tap: Watermelon Blueberry Hard Cider
Offset Bier Co 1755 Bonanza Dr Unit C, Park City offsetbier.com/ On Tap: DOPO IPA
Ogden Beer Company
358 Park Blvd, Ogden OgdenBeerCompany.com
On Tap: 11 rotating taps as well as high point cans and guest beers
Park City Brewing 1764 Uinta Way C1 ParkCityBrewing.com
On Tap: Park City Palmer - Hard Iced Tea
Policy Kings Brewery
79 W. 900 South, Salt Lake City PolicyKingsBrewery.com
On Tap: Kings Proper Kolsch
Prodigy Brewing 25 W Center St. Logan Prodigy-brewing.com
On Tap: 302 Czech Pilsner
Proper Brewing/Proper Burger 857 So. Main & 865 So. Main properbrewingco.com On Tap: Steamy Wonder Rye Steam Ale
A list of what local craft breweries and cider houses have on tap this week
Proper Brewing Moab 1393 US-191, Moab properbrewingco.com
On Tap: Blizzard Wizard Hazy Pale Ale
Red Rock Brewing 254 So. 200 West RedRockBrewing.com
On Tap: Gypsy Scratch
Red Rock Fashion Place 6227 So. State Redrockbrewing.com
On Tap: Grand Bavaria
Red Rock Kimball Junction 1640 Redstone Center Redrockbrewing.com
On Tap: Bamberg Rauch Bier
RoHa Brewing Project 30 Kensington Ave, SLC RoHaBrewing.com
On Tap: My Neck and Maibock
Roosters Brewing
Multiple Locations RoostersBrewingCo.com
On Tap: Cranberry Lime Seltzer
SaltFire Brewing 2199 S. West Temple, South Salt Lake SaltFireBrewing.com
On Draft: Hot Blonde Summer Ale
Salt Flats Brewing 2020 Industrial Circle, SLC SaltFlatsBeer.com
On Tap: OPEN ROAD SERIES #3Barrel Aged Grand Cru
Scion Cider Bar 916 Jefferson St W, SLC Scionciderbar.com
On Tap: SCION CIDER KOALA SHORTS 5.9%
Second Summit Cider
4010 So. Main, Millcreek https://secondsummitcider. com
On Tap: Blackberry Lime 6.5%
Shades Brewing 1388 S. 300 West, Salt Lake City
ShadesBrewing.beer
New Batch: Coyote Ugli (New England Style Double IPA)
Shades On State
366 S. State Street, Salt Lake City
Shadesonstate.com
On Tap: Six Wheat Under Hefeweizen
Silver Reef
4391 S. Enterprise Drive, St. George SGBev.com
Squatters Corner Pub –Valley Fair
3555 Constitution Blvd, West Valley City
squatterscornerpub.com
On Tap: Salt Lake Brewing Co. Emigration Amber Ale
Squatters Pub Brewery / Salt Lake Brewing Co. 147 W. Broadway, SLC saltlakebrewingco.com/ squatters
On Tap: Salt Lake Brewing Co. Bee Sting Honey Lavender Ale
Strap Tank Brewery, Lehi
3661 Outlet Pkwy, Lehi, UT StrapTankBrewery.com
On Tap: “Blood For Ra” American Sour with Tart Cherry and Vanilla; “Pineapple Haze” Hazy IPA with Pineapple
Strap Tank Brewery, Springville
596 S 1750 W, Springville, UT StrapTankBrewery.com
On Tap: “Orange Hopsicle” Hazy Pale; “Trouble” American Sour with Mango and Passionfruit
TF Brewing
936 S. 300 West, SLC TFBrewing.com
On Tap: Twelve taps and high point cans available.
Talisman Brewing Co. 1258 Gibson Ave, Ogden TalismanBrewingCo.com
On Tap: Thirst trap (watermelon wheat); Lucky punk (pilsner)
Thieves Guild Cidery 117 W. 900 South, SLC thievesguildcidery.com
On Tap: Death and Decay Rosé - 6.9%
Top of Main Brewery
250 Main, Park City, Utah topofmainbrewpub.com
On Tap: Top of Main Brewery Hop Carousel IPA
Uinta Brewing 1722 S. Fremont Drive, SLC UintaBrewing.com
On Tap: Was Angeles Craft Beer
UTOG
2331 Grant Ave, Ogden UTOGBrewing.com
On Tap: Golden Grant 5% ABV.
Vernal Brewing
55 S. 500 East, Vernal VernalBrewing.com
Zion Brewery
95 Zion Park Blvd, Springdale ZionBrewery.com

Logan’s Prodigy Brewing returns local flavor to Cache Valley’s beer nerds.
BY MIKE RIEDEL comments@cityweekly.net @utahbeer
The Logan, Utah roadie continues on from last week’s sojourn to Cache County, as I stop into Prodigy Brewing Company, Logan’s first brewery since the early 20th century.
Prodigy - Yellow Snow: A tasty take on the classic American steamer style, this beer takes the palate for a ride, with a more malt-driven approach. If you’re looking for something slightly more bready, this brew will prove that being “on the malty side” is a wonderful thing when executed with this level of taste and balance.
It pours a beautiful amber-copper, hinting at the richness within. The initial taste is quite welcoming, dominated by a lovely malt character that carries distinct notes of brown sugar and caramel. It’s sweet, but in a rustic, comforting way that never feels cloying. This initial richness, however, is just the first act.
As we get into the first swig, a really cool transformation occurs: The sweetness gracefully recedes, and the profile dries out, becoming decidedly more toasty. It’s like the difference between bread dough and a perfectly browned crust. Just as this toasty note establishes itself, the hops emerge to complete the picture. They introduce a subtle but firm pine and herbal profile, providing a balancing bitterness that scrubs the palate clean. The hop bill is what allows the beer to finish on the drier side, leaving you with a crisp, refreshing and incredibly satisfying aftertaste.
Verdict: This is a beer that’s both complex and highly drinkable at 5.0 percent. I didn’t even know I was craving a steam beer until I had this. It’s a reminder of how deeply satisfying a bal-
anced, traditional style can be, scratching an itch you didn’t realize you had. A truly nice brew.
Prodigy - What The Helles?: This is a traditional German pale lager known for its bright, golden color and easy drinkability. It’s typically characterized by a subtle malt sweetness, balanced with delicate hop flavors and a clean, crisp finish. This lager isn’t exactly a masterclass in the style, but it’s designed for pure, uncomplicated enjoyment from the moment it hits the glass.
It poured a brilliant, yellow straw gold, animated by a constant stream of lively carbonation. This energy built and sustained a stubborn quarter-finger head that seemed to last the entire drink, leaving a delicate lace ring down the glass with every satisfying sip. The aroma is equally clean and inviting, presenting a mild graininess alongside sweet malts. There’s a distinct and pleasant grassy character, reminiscent of a Nobel pilsner, which adds a layer of rustic charm.
On the palate, this beer is exceptionally smooth and clean. An initial, slightly sticky sweet malt presence greets the tongue, but this is where the beer’s true intent lies—in its simplicity and balance. To summarize the palate, a slightly herbal and grassy hoppiness emerges to introduce mild dryness, mixing with that sweet edge. It’s a nicely balanced act that never lets one element dominate the other. The finish is clean and clear, a refreshing conclusion that is both relaxing and keeps the drinker interested.
Verdict: This 5.0 percent lager is the kind of beer that makes you keep drinking, not through aggressive flavor, but through its simplicity. It’s almost too easy to drink, and that is perhaps its highest compliment. A well-balanced and dangerously crushable beer.
I highly recommend making your way up to Logan and checking out Prodigy. The pub is long and spacious, and allows for families. You also get an assortment of “high point” beers, whether to enjoy there or take home. If you’re a beer nerd (or a pack of beer nerds), it’s also close to its new neighbor Home Range Brewing, two blocks north on Main Street—making your brewery crawl practically effortless. As always, cheers! CW






BY ALEX SPRINGER @captainspringer

After more than 25 years in business, the team at Trolley Wing Company announced that they would be closing the restaurant’s remaining locations in Taylorsville and Midvale. Over the years, this restaurant became a Utah institution for fans of sports bars and chicken wings, and Trolley Wing Company was a long-time fixture in City Weekly ’s Best of Utah Awards for the best wings in the state. The owners made the announcement via social media, but did not disclose any reasons as to why they had decided to cease operation. It’s always sad to see a

local, community-driven spot close its doors, and we’ll definitely miss this place’s presence in our dining scene.
The Grand America Hotel (grandamerica.com) recently appointed Chef Christian Ojeda as the hotel’s Executive Chef. As part of Ojeda’s role, he will oversee the hotel’s banquet programs, in-room dining and Laurel Brasserie & Bar. Ojeda is a Utah native with Chilean ancestry, and he’s been making waves at Bernardus Lodge & Spa in Carmel Valley, CA. Ojeda also has experience with Utah resorts; he worked at Montage Deer Valley in Park City for nearly 10 years before his time at Bernardus. Ojeda’s career has emphasized sustainability, innovation and mentorship, and we look forward to seeing what he’ll do.
Kiitos Brewing (kiitosbrewing.com) will be hosting a Crafts and Drafts community event on Aug. 9 from 4 p.m. - 9 p.m. Regular attendees of Kiitos’ events can expect the same level of casual charm, beer on tap, tasty bites and pinball while they peruse wares from local makers. In addition to doing some shopping, attendees can participate in their own make-and-take crafts at the venue’s craft station. Kiitos always does a great job with their community events, and previous iterations of Crafts and Drafts have been a lovely way to mingle with downtown’s coolest and most creative people. Throw some cold beer, hot food and pinball in the mix, and you’ve got yourself a hell of a good time.
Quote of the week: “A man who lies about beer makes enemies.” – Stephen King









Whether it’s new parts, new sheet music or just a new instrument in general that is needed, it’s important to have a reliable place to which one can turn. Thankfully, the Wasatch Front is studded with knowledgeable locations to utilize for every kind of musical need. They may not toot their own horn themselves, but our readers certainly will.



BY EMILEE ATKINSON eatkinson@cityweekly.net @emileelovesvinyl
The weather is hot, but the local releases are even hotter. Here are more new (ish) songs to check out from incredible musicians in the area.
Tariq Abou-Bakr, “Folk Music Man”: This new single from singer/songwriter AbouBakr is the epitome of folk music. It’s passionate, full of emotion and has a great acoustic sound. With help from the folks in The Proper Way, “Folk Music Man” is a pure joy to listen to. Abou-Bakr’s vocals are poignant, featuring just the right amount of grit. Folk is a special genre with how it paints beautiful pictures using sound and lyrics, and how songs of the genre are amazing in terms of storytelling—not that other genres don’t do that, but folk music just stands out in that regard, especially with Abou-Bakr’s signature sound.
Peech., Small Town America: Another artist who offers lovely folk sounds, Peech. will be coming back to his home state of Utah to debut his new EP, Small Town America. While Peech. (Harry Lawson) has since moved to Nashville, we can still rejoice in his new EP and claim him as our own. Small Town America delivers a collection that feels both deeply personal and universally relatable. It’s a story of growth, nostalgia and chasing the unknown, told through vivid lyricism and intimate vocals. “It’s a journey through small-town memories and the dreams of a world beyond,” Lawson shared. “It’s about moving forward, letting go of heartache and hardships while holding onto the warmth of home. It’s about missing the beauty, the connections and the moments that shaped you, yet embracing the thrill of the unknown.” The EP is full of songs that feel touching and sentimental, with a dash of heartbreak. One of the tracks, “Be Together,” has a mix of emotions that will have you thinking back to your hometown and memories of being
young, whether good or bad. Small Town America will be streaming everywhere Aug. 22.
The Moss, “Darkness”: The Moss, a jovial surf rock band out of SLC, released a new song for the first time in a year, titled “Darkness.” One has to wonder if The Moss are a little in their feelings right now, because their last two singles have had a more melancholy tone—not that it detracts from their enjoyable sound in the slightest. “Darkness” showcases a lamenting, yearning sound, but remains a good listen. The vocals are incredible, and the track has a full sound with a lot of elements happening simultaneously that will make you want to revisit it over and over.
Rachael Jenkins, “Body”: “I wrote this song back in 2022 and since then, it’s served as a mantra,” Jenkins said of her newest single. “I’m having a great time / I’m not really angry / I’m willing to take the long way home / I’m in love with my body whether nobody or everybody is watching,” she sings. “More than anything, ‘Body’ is about trying to let go and forgiving yourself when you don’t get it quite right. Being alive is a blessing and a bitch—can’t have one without the other, so you can at least try to be kind to you and yours along the way.” Singer/songwriter Jenkins is known for her beautiful, yet heart-wrenching tracks that capture a wide range of emotion through her gorgeous vocals and harrowing lyrics. “Body” is no different—it opens with Jenkins and an acoustic guitar and builds as you get to the chorus. This is a strong entry in Jenkins’ library that offers a refreshing new sound for listeners to enjoy.
19 Miles Per Hour, “Love Is…”: 19 MPH are a beloved pop/punk rock band in the local scene. They’re energetic, exciting and write music that’s relatable to everyone. “Love Is…” is an awesome summer track that is fun and so easy to dance to. Plus, there’s a visual component to accompany the release, for as the band notes on their website, “don’t miss the nostalgic, butterflies in your stomach video.” Not only does 19 MPH make great music, but they care a lot about the community, consistently raising awareness for mental health, the LGBTQ+ community, Alzheimer’s research and other charitable efforts. “19 Miles Per Hour is more than just a band; they’re a communityminded group dedicated to creating change through their

music,” their website notes. “With a growing reputation for delivering unforgettable live shows, they bring the energy to every performance, ensuring their fans always have an amazing time. Through their music, activism, and passion for connection, 19 Miles Per Hour is committed to making a difference in the world.”
No Horizon, self-titled EP: New Horizon is a new, fresh group in the SLC metal scene. Their debut show was on July 25, celebrating their self-titled EP that was released at the end of May. Their sound is inspired by djent and metalcore elements and they rock hard what else can I say? If you’re a metal fan and you need something new, you definitely need to check out No Horizon. “Drawing inspiration from bands like Currents and Invent Animate, they craft powerful, emotionally charged music that merges technical prowess with explosive energy,” they note on their online bio. This new EP is punchy, loud and in your face, as metal should be. CW





TUESDAYS

WEDNESDAYS









If you’re in the mood for some punk, psych and rock vibes, this is a show you won’t want to miss. Headlining is Cosmic Fates, an SLC trio that pulls inspiration from classic and alt rock, shoegaze and a dash of psych. “Cosmic Fates aspire to create a sonic journey through the complexities of the human experience,” their website details. They released their self-titled debut EP back in 2023, offering a great introduction to their sound. They followed that up with their February 2025 release “Restless Heart,” an alt/rock track that’s perfect for any rock playlist. Cosmic Fates’ sound is more refined here and really showcases their talent. Also joining the show is Voltmetre, a local heavy-groove band. This group is definitely inspired by the rockers of yesteryear, making you feel nostalgic while getting to experience something new. With one of the best punk band names ever, Johnny Tightlips rounds out the bill for the evening. According to their website, these guys have been jamming together since 2005, and you can definitely tell they have a handle on the genre and what it’s all about. It’s punchy punk rock that’s fast and loud, and sometimes that’s all you need in life. Come rock out at Pearl on Main on Friday, Aug 8 at 7:00 p.m. (Doors at 6:30 p.m.) Tickets for the all-ages show are $12.86 in advance and $18.51 the day of the show. Grab tickets at 24tix.com. (Emilee Atkinson)

















All taste is subjective and inherently correct, because it’s yours and yours alone. However, if you have never witnessed the righteous chant-along skank of the Floridian ska-punk troupe Less Than Jake, now is the time to expand your palate. Sound-hopping isn’t a bad thing, and this band right here checks a lot of boxes: horn parts, catchy melodies, hybrid musicality, etc. All in on the circus style mayhem this time around with clowns, beach balls, toilet paper cannons and jugglers, Less Than Jake truly is having the most fun. “We don’t really have a formula or expectations of ourselves. It’s just very natural. I think that’s one of the reasons why we’ve been able to stick around so long is that we actually love all of our songs,” bassist Roger Lima told RVA Mag. “We always wrote our songs with the right intentions; we never were trying to fit into any mold or anything. So, they’re still fun to play. It still feels like us, and I think we’re lucky in that way.” Joining them is the brilliant genre-bending legends, Fishbone. Far too eclectic for most who can only handle one style, they bring a frenetic fusion of all things rock/funk/boogie/soul/punk/ska to one incredible and special group—and Angelo Moore is one of the greatest frontmen ever. Alongside Fishbone, The Suicide Machines and Catbite open. Catch all of these acts on the Summer Circus tour at The Union on Friday, Aug. 8. Doors open at 5:30 p.m. and show starts at 6:30 p.m. Tickets for the all-ages show are $44.85 and can be found at ticketmaster.com. (Mark Dago)




Das Energi @ The Saltair 8/8 – 8/9



It’s already that time of year again when the biggest electronic music festival in Utah takes place at the iconic Great Saltair venue. Some of the biggest artists will be playing, like tearjerker Illenium (known for his songs “Good Things Fall Apart” and “Back to You”), fun bounce house from Chris Lake (known for “Operator”) and dark dubstep VOYD (Svdden Death’s even darker alter ego). There’s always a little bit of everything for ravers of all musical tastes, making it the most anticipated annual event. With three stages—indoor, main stage outside and beach stage—you can expect Decadon incorporating his electric guitar, Isoxo with his high-energy headbangers and KREAM holding it down for the house and techno fans. There will also be some new sets you don’t want to miss, like Malaa’s Alter Ego, Fransis Derelle’s melodic dubstep alter ego afterxheaven, Chibs b2b with Subfiltronik and Benda b2b OG Nixin. Explore the vendors along the beach and get some pics while the sun is setting against the Great Salt Lake. Come early to catch local DJs and stay until the end to see the fireworks behind the main stage. Join the fun at The Great Saltair on Friday, Aug. 8 and Saturday, Aug. 9. For Friday general admission, tickets cost $156; Saturday GA costs $168; two-day General Admission tickets cost $298. Charging lockers are available for purchase, as well as shuttles to downtown. Go to dasenergifestival. com for full event information. (Arica Roberts)
Naturally, there’s no substitute for the real deal, but when the real deal no longer exists, then an alternative has to be found. Such is the case with the Australian Pink Floyd Show, who have proved their worth by selling over five million tickets to concerts in some 35 countries worldwide. Described as “The Gold Standard,” they replicate the sights and sounds of a band that set a gold standard of its own and defied any attempt at imitation. Nevertheless, these five musicians from Adelaide have managed to do just that. When they converged in 1988, they performed Floyd songs for their own amusement, but now, some 37 years later, they’re so accomplished that Floyd guitar-
ist David Gilmour chose them to perform at his 50th birthday celebration. Utilizing state-of-theart lighting effects, lasers, and animation projected onto a huge overhead screen, they create an audio and visual extravaganza that effectively transports their audiences back to the heady days of Britain’s ‘60s psychedelic scene, a time when music effectively stretched the boundaries of intrigue and imagination. This particular tour celebrates the 50th anniversary of Wish You Were Here, Floyd’s chart-topping, multi-million selling ninth album that the band itself named as one of its faves. Welcome to the machine that is the Aussie Pink Floyd Show. To borrow the title of one of the tracks, missing it will find you wishing you were there. The Australian Pink Floyd Show: Wish You Were Here 50th Anniversary performs at 7 p.m., Sun Aug. 10 at Sandy Amphitheater. Tickets cost $72 - $107. Go to ticketmaster.com. (Lee Zimmerman)
Affectionately known as “That Little Ol’ Band from Texas,” ZZ Top are easily one of the most beloved American outfits of all time. Formed in Houston in 1969, they morphed out of a little-known band called the Moving Sidewalks, and though their music was originally based around basic blues and boogie, they quickly outgrew those seminal stereotypes to develop a sound all their own. Early albums Tres Hombres and Fandango became their initial stepping stones, leading to 1980s mainstream success with such songs as “Gimme All Your Lovin’,” “Legs” and “Sharp Dressed Man.” Nevertheless, it was their indelible image—that of guitarist Billy Gibbons and bassist Dusty Hill paired up with beards, sunglasses, hats and synchronized choreography—that’s so instantly identifiable. Ironically, drummer Frank Beard was the only band member without facial hair. Sadly, after a half-century combined career, Hill passed away in 2021, only to be replaced by his guitar tech, Elwood Francis. In the meantime, Gibbons took a side path into a solo career. Nevertheless, the band—and the brand—are still going strong, touring consistently and sharing the style that immortalized them as ageless icons. A Grammy-nominated documentary, aptly dubbed That Little Ol’ Band from Texas, shares their story while a new album of newlyrecorded classic tracks serves as its soundtrack. And yes, they remain not only sharp-dressed men, but extraordinarily entertaining musicians as well. ZZ Top performs at Red Butte Garden at 7:30 p.m. on Wednesday, Aug. 13. Tickets cost $92.50 for Red Butte Garden members and $97.50 for the general public at etix.com. (Lee Zimmerman)
BY ROB BREZSNY
ARIES (March 21-April 19)
The Tagalog word gigil refers to the urge to squeeze or pinch something adorable—an ecstatic tension that verges on overflowing the container of decorum. In the coming weeks, you Aries could feel gigil for the whole world. Everything may seem almost too vivid, too raw, too marvelous and altogether too much. I advise you to welcome these surges and allow them to enhance your perceptions. Laugh hard. Cry freely. Invite goosebumps. Please note: Don’t actually squeeze anyone without their permission.
TAURUS (April 20-May 20)
In Japan’s snow country, artisans practice yuki-sarashi It involves laying woven cloth on snow under sunlight to bleach, brighten, purify and soften the fibers through the effects of snow, sunlight, cold and ozone. Because this doesn’t require harsh chemicals, it maintains the fabric’s strength and prevents yellowing over time. I propose you make yuki-sarashi a useful metaphor, Taurus. Something fragile and fine is ready to emerge, but needs your gentle touch and natural methods. You are often grounded in the adept manipulation of material—what works, what holds, what can be relied on. But this burgeoning treasure needs maximum nuance and the blessings of sensitive care.
GEMINI (May 21-June 20)
When African American dancer Josephine Baker arrived in Paris in 1925 at age 19, she was seeking refuge from her home country’s racism. Her electrifying performances soon made her a celebrity. Author Ernest Hemingway said she was “the most sensational woman anyone ever saw.” As she grew wealthy, she donated generously to French charities, hospitals and schools. Her compassionate works evolved further, too. During World War II, she worked as a spy for the French Resistance against the Nazi occupation. Later, she became a civil rights activist in the US. Can you guess the astrological sign of this multi-faceted star? Gemini! I hope you will be inspired by her in the coming weeks. May you, too, use your natural gifts and stylish flair to serve the greater good. Look for opportunities to mentor, encourage and advocate for those lacking your advantages.
CANCER (June 21-July 22)
When a glacier moves, it doesn’t rush. It presses forward incrementally, reshaping mountains, carving valleys and transporting boulders. In a metaphorical sense, Cancerian, you are now in glacier time. A slow, relentless and ultimately magnificent process is afoot in your life. Others may not yet see the forward momentum. Even you may doubt it. But the shift is real and permanent. Trust the deep, inexorable push. Your soul is hauling whole landscapes into new configurations.
LEO (July 23-Aug. 22)
In the Arctic, the sun shines for 24 hours a day during midsummer. There is no night, only the surreal glow of prolonged gold. The human body, confused by the unending day, may be unsure about when to sleep. For some, this creates disorientation, and for others, a strange euphoria. In my astrological opinion, Leo, you have entered a metaphorical version of this solar dreamscape. Your creative powers are beaming like a relentless sun. There may be little darkness in sight. So how will you rest? How will you replenish under the glow of fervent possibility? Be wisely discerning with your energy. Don’t mistake illumination for invincibility. Bask in the light, yes, but protect your rhythms.
VIRGO (Aug. 23-Sept. 22)
Now is an excellent time for you to swear sacred oaths. I suggest you get less comfortable with transitory arrangements and short-term promises. The near future will also be a ripe phase to make brave commitments that require you to go farther and deeper than you’ve dared to before. I recommend you forgo the cheap thrills of skipping along from one random moment to the next. Embrace a game plan. Finally, I urge you to cast magic spells on yourself that will release your unconscious mind from old fixations that subtly drain your power to fulfill your dreams. Please,
please, please surrender trivial obsessions that distract you from your life’s key goals.
LIBRA (Sept. 23-Oct. 22)
In West African traditions, griots are key figures in their communities. They serve as storytellers, oral historians, poets, genealogists and advisors. Their presence is often central to events like weddings, funerals and ceremonies. In the coming weeks, Libra, I hope that you will embrace a role that resembles the griot. Your ability to enhance and nurture your network is at a peak. You have extra power to weave together threads that have become frayed or unraveled. Given your potential potency as a social glue, I advise you to avoid gossip and instead favor wise, kind words that foster connection.
SCORPIO (Oct. 23-Nov. 21)
The phrase “elegant sufficiency” is an old English expression meaning “just enough” or “a sufficient amount in a refined or tasteful way.” I am expanding it to also mean “the simplest solution that solves a problem completely without unnecessary complexity.” It’s your power phrase, Scorpio. What you need is not intricate perfection, but elegant sufficiency: enoughness. I suggest you welcome this gift with enthusiasm—not in a resigned way, but with a quiet triumph. Maybe your plan doesn’t need more bullet points. Maybe the relationship doesn’t require further analysis. Maybe your offering is already thorough. Allow yourself the sweet satisfaction of having just the right amount. What you have created may be more organically whole than you realize.
SAGITTARIUS (Nov. 22-Dec. 21)
How do you become a maestro of desire? What must you do to honor your beautiful yearnings and cull your mediocre ones? What’s the magic that will help you fulfill your life’s purpose by trusting your deepest cravings? Here are some tips. First, jettison your inessential desires and cherish the precious yearnings that are crucial. Second, dispose of outmoded goals so you can make expansive space for robust goals that steer you away from the past and guide you toward the future. These are challenging tasks! The very good news is that the coming weeks can be a turning point in your quest to claim this birthright.
CAPRICORN (Dec. 22-Jan. 19)
I’m writing a fairy tale about an ancient land whose queen regards poetry as essential to the public good. She often invites poets to perform for her and her court. When they finish a stirring passage, they bow—not to the queen or other observers, but to the silence they mined to access their inspiration; to the pregnant chaos from which the poem was born. The pause is a gesture of gratitude and acknowledgment. I invite you to partake in similar acts of appreciation, Capricorn. Bow toward the mysteries from which your blessings flow. Honor the quiet sources that keep you fertile. Praise the treasures in the dark that fuel your intense activities.
AQUARIUS (Jan. 20-Feb. 18)
When I advise you to get naked I’m not necessarily suggesting that you doff your clothes. What I primarily mean is the following: Shed the armor around your heart; strip off your defense mechanisms; discard knee pads you wear while kissing butt or paying excessive homage; recycle shoes, jackets, pants and opinions that don’t fit you; and discard pride-spawned obstacles that impede your communions with those you love.
PISCES (Feb. 19-March 20)
The Finnish word sisu describes a radical, unglamorous persistence. Those who possess sisu can summon extraordinary determination, tenacity and resilience in the face of confusion or difficulty. It’s not about bravado or flair, but about soulful gutsiness. I suspect it’s time for you to draw on your sisu Pisces. It will empower you to tap into reserves of strength that have previously been unavailable. You will activate potentials that have been half-dormant.
A NEW DAY SPA
4970 SOUTH 900 EAST #J MURRAY UT 84117
801-272-3900
WWW.ANEWDAYSPA.COM





According to ApartmentList.com, the apartment vacancy rate rose to 7.1% in July. The outlet noted that the market “has passed the peak of this latest construction boom … it is still overbuilt relative to demand.”
It’s become more of a renter’s market than a landlord’s market, where rents seem to just escalate often. The report also found that last year, more than 600,000 new apartments came on board in this country, representing a 65% increase compared with 2022, with the newest supply in a single year since 1986.
Although rents didn’t change much in July over June, the number of days an apartment is on the market before finding a tenant decreased to 28 from 37 days in January.
Rents nationally were down 0.08% from the same month, but stats are showing that rents peaked earlier this year and rent growth has stalled during the peak moving season: summer.
Basically, rents are still high, but the market is sluggish with vacancy rates in some areas at an all-time high. Ask any 20-something who’s renting right now and they may say that half their paycheck is going toward rent. Houses for rent will typically be more expensive than apartments, and the more amenities a landlord offers, the higher the rent (swimming pool, gym, dog wash, etc.). A good adage is, “The more expensive the neighborhood to buy in, the more expensive it is to rent there!”






1. Nickelodeon character with a heartbreaking viral video in which he finds out his show has been canceled
9. Side, back, cottage, and jowl, e.g.
15. Match
16. Music genre that fits in with Hot Topic
17. Slowpokes
18. Cold sore treatment brand
19. “The Westing Game” author Raskin
20. Tucked in before bed?
22. Battle of Hastings region
24. Brown, e.g.
25. Pit
26. Ltd., across the Chunnel
27. Order
29. Guinea pig lookalikes
30. ___ Octavius (“Spider-Man” villain)
32. Navel scraping?
34. Bridge component
36. Title seventeen-year-old on Broadway
39. Low-quality images?
43. Tricked
44. Macron’s head
45. Night sch. course, maybe
46. It comes before a fall
47. Prefix meaning 10 to the 18th power
48. Match single socks again
51. Singer-songwriter, e.g.
54. Aleppo’s country
55. Invader of the Roman Empire
56. Abstainer’s mantra
58. Group of infected computers
59. Like many half-courses
60. Most distant point
According to Zillow, the average rent in Utah for 2024 was $1,850. Apartments.com data is showing that rents are down in 2025 statewide, with an average of $1,399 per month, Salt Lake County’s average rent is reportedly $1,324, Utah County is between $1,700 and $1,800, Weber County is $1,475 and Washington County is $1,863.
This data points to the fact that many who lease are rent-burdened, which delays them from buying a home because they can’t save much toward a down payment and closing costs.
This also filters down to the demographic waiting to get married and starting a family.
There were just over 20,000 apartments under construction last year in the Salt Lake City metro area, with a projected build of around 8,300 units in 2025. One study suggests that in Provo alone, construction starts for 2025 were at one-third of their 2022 peak.
This is the time of year for the annual Salt Lake Parade of Homes. There are some nice ones for sure, but I don’t see any listed to visit that are priced under $500,000. President Donald Trump keeps pressuring the Federal Reserve to substantially lower interest rates, but that could crash our economy.
Sales are down 2% to 3% for all housing types in the state, but there are more listings over last year (up 8% in May), which is great for buyers seeking options in homes or condos. If you can jump into looking to buy, there are deals out there. In this sluggish market, sellers may offer to pay buyers closing costs and reduce the price to sell their property. ■

5. “So Wrong” singer Patsy
6. Rush, quaintly
7. Caldecott Medal winner ___ Jack Keats
8. First-come, first-served arrangement, maybe
9. Like suspicious eyes
10. Prefix with valent
11. Diversion where the walls may have ears?
12. Easy area to pass to, in hockey
13. Devotional periods
14. Lean to the extreme
21. 50-50 shot
23. Nelson Mandela’s native tongue
61. Like some livestock
1. “Wrecking Crew” guitarist Tommy (whose surname means “German” in Italian)
2. Capital of the territory featured in Netflix’s “North of North” (2025)
3. { }, mathematically
4. Certain locks
28. 1990s tennis star ___ S·nchez Vicario
29. Montblanc product
31. “Lecture ___” (John Cage text first delivered in 1950)
33. Irretrievable item
35. Actor Philip of “Kung Fu”
36. “Wicked: For Good” character
37. Elite
38. Get comfortable with
40. Discover
41. Small opening where spores are released
42. Like some skirts or slacks
47. On the maternal side
49. Twisty curves
50. They’re hard to believe
52. Former Ozzy Osbourne guitarist Jake
53. Bahrain ruler
57. “De ___ Vez” (Selena Gomez single)
week’s answers


Complete the grid so that each row, column, diagonal and 3x3 square contain all of the numbers 1 to 9. No math is involved. The grid has numbers, but nothing has to add up to anything else. Solve the puzzle with reasoning and logic.
When a certain intern started her summer job at Sidley Austin in New York City, she made her mark by biting another employee—for which she was not immediately fired, Inc. magazine reported on July 28. Nope—instead, the law firm tolerated the behavior through five victims, presumably because the biter was “otherwise personable and there was some reluctance to elevate the matter.” However, employment a ttorney Dan Schwartz said that even if she has a disability that compels her to bite other people, “The ADA does not protect an employee at the expense of another employee.” Vampire lawyers, indeed.
As Albert Cutler was driving home from church on July 27, he noticed a bald eagle flying over the highway in Okauchee Lake, Wisconsin. The eagle was carrying a fish—until it wasn’t, and as Cutler watched the fish fall, he wondered if he had hit it with his car, FOX6TV reported. Upon arriving home, Cutler’s daughter located the fish, stuck in the grill of his truck. The largemouth bass went into the family’s fridge, and Cutler s aid it’s the “biggest bass” he’s ever caught.
In August 2023, News of the Weird reported the arrest of Calese Carron Crowder of Glendale, California, for the unusual fetish of butt-sniffing. Now the man is back in the news: According to KTLA-TV, Crowder was arrested on July 22 at a Walmart in Burbank after he allegedly crouched behind a woman at Nordstrom Rack and “inappropriately sniff(ed) her buttocks.” Crowder, who’s a frequent flyer with Los Angeles County, was on active parole for his previous offenses and had his bail set at $100,000. “He needs to be put away for good,” said one alleged victim.
The U.S. Coast Guard’s newest recruiting office is open—in Omaha, Nebraska. KETV reported on July 19 that the USCG’s goal is to increase its workforce by 15,000 over the next few years, so they’re heading inland. The Omaha office will serve a landlocked region including parts of Iowa, South Dakota and Kansas. “If we’re not here, then (people) have to travel hundreds of miles, sometimes get on a plane to go to a recruiting office,” said Gregory Watson, recruiter in charge.
Animal Antics
■ Visitors to Grand Teton National Park in Wyoming responded in a surprising way to a wily fox nicknamed the Sneaker Snatcher, The New York Times reported on July 17. The National Park Service posted “wanted” signs to warn campers that a fox was stealing shoes from campsites, but as the total number of shoes ballooned to 32, park staff realized people were intentionally leaving their footwear accessible to the fourlegged Jesse James—“just in case he visits.” A video posted to Instagram pleads with visitors: “Don’t bait wildlife with belongings. Feeding or encouraging wildlife can put animals at risk,” the park advised.
■ E arly on July 26, as Katherine Vanbuskirk let her dogs out on her deck in Somerville, Massachusetts, a raccoon jumped at her, clawing her face and scratching her arms as she tried to fight it off, WFXT-TV reported. Vanbuskirk was able to get away from the raccoon and close her deck door, and she called 911. “I just encountered a monster,” she said. “All I could do was scream, ‘ Help me! Help me!’” She was treated with antibiotics and rabies shots at the hospital.
In an unlikely brand extension, Coors Brewing Co. is pitching Dura Chill, an underarm deodorant that should be refrigerated before application, KDVR-TV reported on July 29. The limited-edition hygiene product is said to smell like the breezes of the Rocky Mountains. “Coors Light is all about helping people ‘Choose Chill,’”
said Marcelo Pascoa, vice president of marketing for the brand. “Dura Chill is like giving your underarms their own ice-cold beer.” The deodorant, available on the company’s website, sells for $14.99 and is limited to two per household.
At the Savannah River Site nuclear facility in Aiken, South Carolina, a team found a nest of wasps near a tank on July 3, WCVB-TV reported on July 30. The nest was sprayed, then checked for radioactivity, reading at 100,000 dpm—about 10 times the level of radiation allowed by federal regulations. The nest was bagged as radiological waste, and officials said the surrounding area was uncontaminated. The Savannah River Site became an EPA Superfund site in 1989 and no longer has functioning reactors.
CBS News reported on July 25 that an unnamed man in Argentina won a court appeal against Google for “harm to his dignity” after the company’s Street View camera captured him walking around his yard naked. The dispute began in 2017, when the man and his house, with the house number clearly visible, were posted to Google’s system. He said the images exposed him to ridicule at work and among his neighbors. A lower court ruled against him, saying he was “walking around in inappropriate conditions in the garden of his home,” but appeals judges disagreed and awarded him about $12,500. “The invasion of privacy is blatant,” they wrote.
When an unnamed man got caught after stealing Smokey Bear signs from state forests in Florida, Smokey himself was on hand to aid in the arrest, WTSPTV reported on July 31. Agriculture Commissioner Wilton Simpson said the suspect had traveled from Pensacola to Orlando, lifting the signs and posting them on Facebook Marketplace for $1,900 each. Smokey held the door open for the perp as he entered the patrol truck and was seen in the driver’s seat after the arrest.
After the large earthquake on July 29 in western Russia, tsunami warnings were communicated all the way to the U.S. West Coast. A Norwegian Cruise Lines ship docked at Hilo, Hawaii, took heed and left the port for the safety of its guests. But a group of passengers who were still on shore got the warning of the ship’s departure too late, KHON-TV reported. Eric Anderson and his f ather were separated from their family, who had gone back to the ship. Anderson said the ship had texted that it would leave at 4 p.m., but it departed closer to 3:30. Fortunately, local residents transported the stranded passengers to Waiakea High School, where they spent the night. They were reunited with their families on July 30 after the warnings were canceled.
Boy, Chuck E. Cheese is a hotbed of weird behavior these days. This week’s installment involves a brawl that took place on July 26 at a location in Mobile, Alabama. WKRG-TV reported that witnesses said about 20 people were fighting because a teenage boy “got upset about something.” “They started fighting as I was walking by,” said a girl who was hit in the face, “and then they punched me on accident.” The Mobile Police Department is investigating by watching surveillance video and reaching out to those involved. Public Information Officer Roderick Miles advised that people in such circumstances “try to do something that’s going to result in better decisions than fighting at a freaking Chuck E. Cheese.”






















